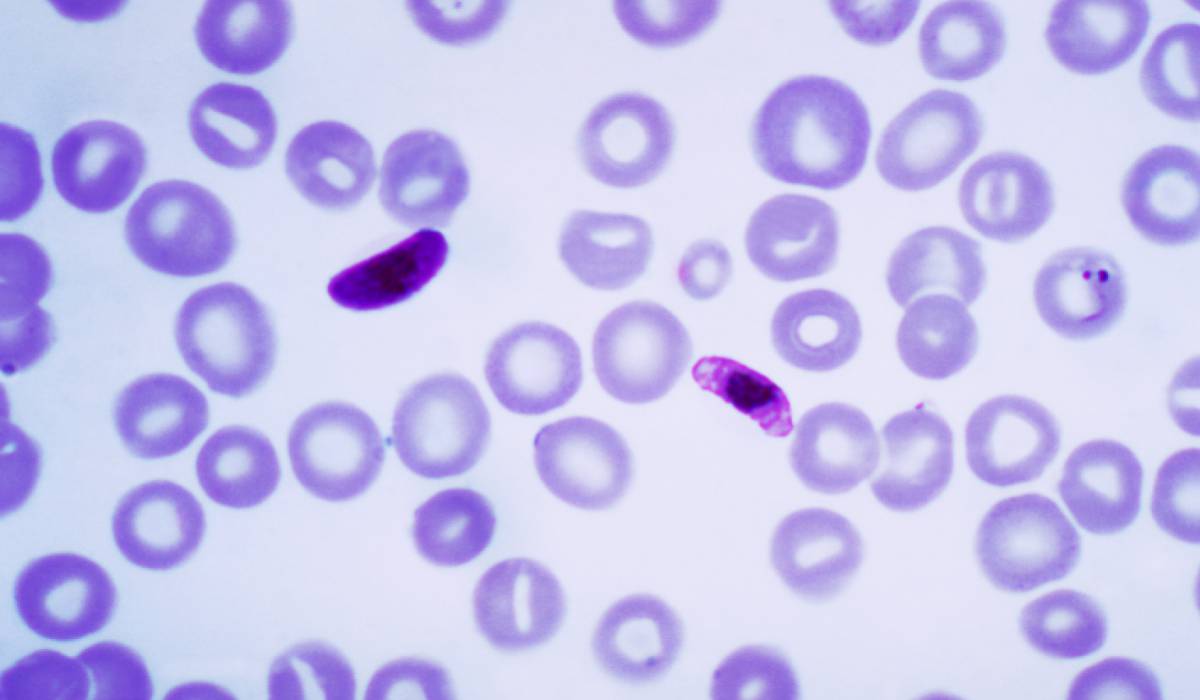
Muestra de sangre que contiene varias formas del par&aacute;sito de la malaria, 'Plasmodium falciparum'

Manipulando genes contra la malaria
Una eficaz vacuna experimental vuelve a revelar la importancia vital de las técnicas transgénicas para la investigación biomédica; y la de mantener una mente abierta
Una eficaz vacuna experimental vuelve a revelar la importancia vital de las técnicas transgénicas para la investigación biomédica; y la de mantener una mente abierta
 Ampliar foto
Ampliar foto
Contar lobos, aves, grillos, mariposas, encinas… Miles de personas ayudan a mejorar la protección de especies con sus observaciones

'Materia' desafía a sus lectores a resolver este último desafío científico, que acompaña a la biblioteca 'Descubrir la ciencia'

Solo una de cada mil galaxias observadas tienen una forma parecida a la del objeto recién descubierto. Su estudio puede explicar la forma de la Vía Láctea

El hallazgo de dos fósiles de physalis en la Patagonia reescribe la historia de las plantas

En la mayoría de los juegos las reglas se conocen de antemano, pero en el juego de la ciencia no es así

El descubrimiento revela un nuevo modelo de generación de módulos especializados del córtex

Un estudio señala a los contaminantes de los coches como presuntos culpables

Una investigación relaciona el origen de los bienes del comercio global con la extinción de especies

Los recurrentes Estallidos Rápidos de Radio podrían venir de una estrella de neutrones a 3.000 millones de años luz

La bebida japonesa por antonomasia, obtenida a través de la fermentación del arroz, conlleva un complejo proceso bioquímico que el país del sol naciente lleva años perfeccionando

La auxiliar de enfermería española, primer caso de ébola adquirido fuera de África, describe ahora su "calvario"

Esta hembra tenía 105 años y vivía en el Pacífico norte

Podían tardar de tres a seis meses en eclosionar, un periodo muy prolongado que pudo haber influido en su desaparición

Un estudio alerta de que los idiomas son una barrera importante para la ciencia global

La oxitocina fue llamada la hormona del amor pero es fundamental durante los conflictos

Los seres vivos asexuales están más expuestos a los parásitos y las enfermedades

Tras 20 años de misión, la sonda 'Cassini' se prepara para arder en la atmósfera del gigante gaseoso

En 2016, las temperaturas en el Ártico han sido mucho más altas de lo normal

Los científicos lograron activar el sistema inmune usando ejemplares debilitados del patógeno

'Materia' desafía a sus lectores a resolver este noveno desafío científico, que acompaña a la biblioteca 'Descubrir la ciencia'
Un documental de Disney popularizó la idea de que los estos animales se matan en masa, pero su historia es otra
 Ampliar foto
Ampliar foto
Algunos caracoles clavan un dardo a la pareja para favorecer su descendencia

Ganar muchas veces seguidas jugando a la lotería, ¿es cuestión de suerte o es un fraude?

Se cumple en este año el centenario de la muerte de José de Echegaray, catedrático de Matemáticas y premio Nobel de Literatura en 1904

A las máquinas les resulta más fácil emular las capacidades intelectuales de los humanos que sus habilidades motrices

¿En qué se parecen un cuervo y un pupitre?, le pregunta a Alicia el Sombrerero Loco

'The Lancet' publica un artículo muy crítico con los gobiernos por su afinidad con la industria alimentaria

No debemos preocuparnos tanto por los excesos de las fiestas sino por nuestra alimentación durante el resto del año

Ensayos clínicos ponen de manifiesto que el paracetamol no es mejor que el placebo para el dolor crónico de espalda o la artritis
Las actividades excesivas relacionadas con el juego con apuestas, el sexo y el trabajo, ¿pueden realmente considerarse verdaderas adicciones?
 Ampliar foto
Ampliar foto
El análisis fractal de la obra de varios pintores contemporáneos muestra su deterioro mental
El relevo presidencial y las críticas de los republicanos cuestionan uno de los mayores proyectos espaciales defendidos por Obama

Un estudio, realizado con el pez tordo, prueba que estos animales nadan más rápido cuando el agua huele a depredador

La mayoría de estos felinos viven más allá de los límites de los parques que los cobijan

El genetista Carles Lalueza-Fox narra las aventuras tras los análisis de restos de monarcas europeos

La astrónoma estadounidense era una de las favoritas a ganar el Nobel de Física

En mitad de la mediocridad política y la inquietud social, 2016 ha producido grandes avances en la física, la biología y la inteligencia artificial

El autor reflexiona sobre la recurrente práctica de invocar a "reconocidos expertos internacionales" con supuestas terapias tan avanzadas que son desconocidas en España, cuando "el sistema nacional público de salud debería poder hacerse cargo de cualquier paciente de nuestro país"

Un grupo de Barcelona identifica las células del tumor primario que causan las metástasis y la muerte. El trabajo es en ratones, pero promete amplias aplicaciones clínicas en el futuro